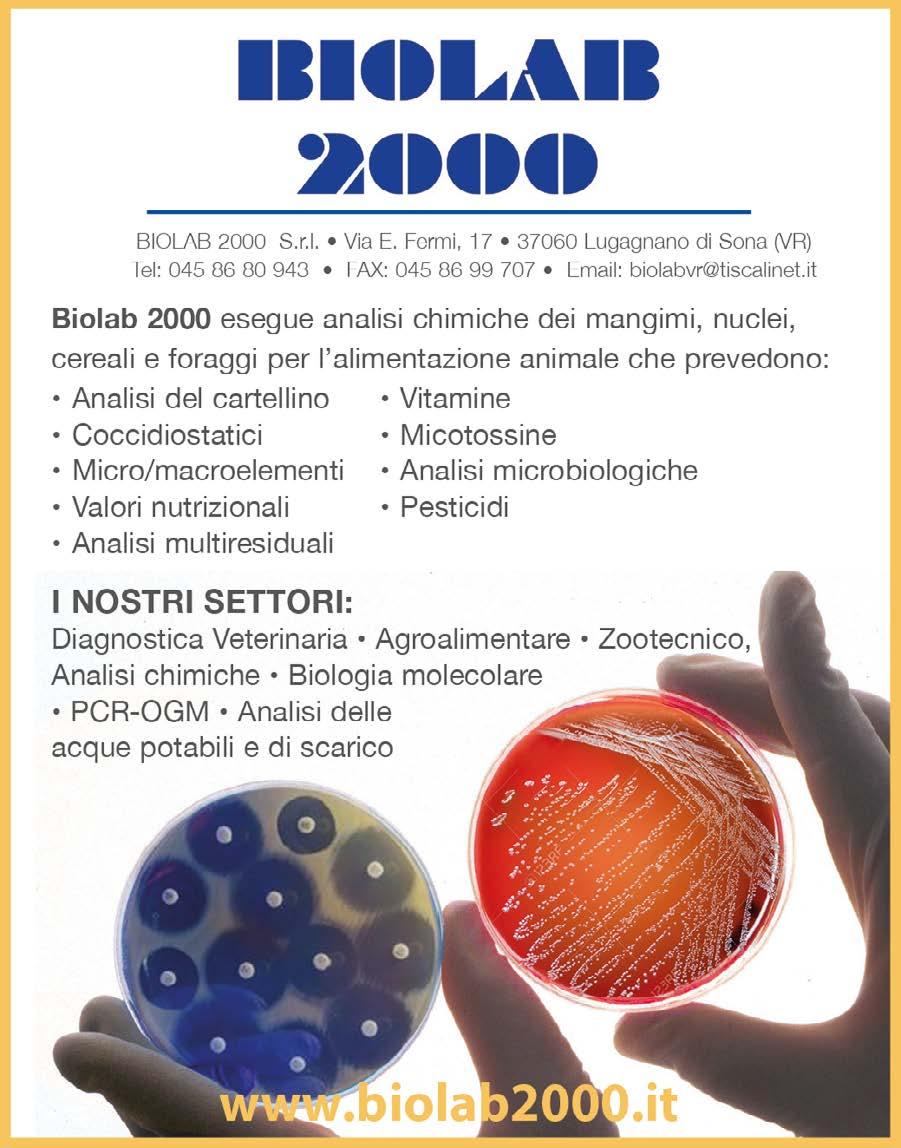

ZOOTECNICA
Rivista avicola

Editore
Amministrazione e redazione
Zootecnica di Marianna Caterino
Via del Forestello n. 8
50063 Figline Incisa Valdarno (FI)
P.IVA IT 07439250486
Telefono +39 055 010 7041
Web: www.zootecnica.it


Direttrice responsabile
Marianna Caterino
Redazione
Giulia Messina zootecnica@zootecnica.it
Marianna Caterino
Cellulare +39 339 11 52 161 marianna@zootecnica.it
Amministrazione amministrazione@zootecnica.it
Registrazione
Periodico mensile registrato presso il Tribunale di Firenze al n. 6215 in data 10/03/2025 Iscrizione al ROC n. 42813
Spedizione in Abbonamento Postale Aut. n° CN-NE/00593/03.2025
Art Direction e impaginazione Pilar Roca – pilarroca.com
Stampa
Faenza Printing
Via Vittime Civili di Guerra, 35 48018 Faenza (RA)
Tutti i diritti di riproduzione e traduzione degli articoli pubblicati sono riservati. È vietata la riproduzione anche parziale senza l’autorizzazione dell’editore. La direzione non assume responsabilità per le opinioni espresse dagli autori dei testi redazionali e pubblicitari.
Zootecnica, in conformità al GDPR (Regolamento UE 2016/679), garantisce la riservatezza dei dati usati per gli abbonamenti e per gli scopi tipici della stampa specializzata e la possibilità di modificarli o cancellarli a mezzo richiesta scritta.
www.zootecnica.it

EDITORIALE

I dati presentati da Unaitalia in occasione della recente assemblea nazionale confermano la solidità della filiera avicola italiana: nel 2024, produzione e consumi di carni bianche sono cresciuti rispettivamente del +3,6% e del +3,7%, con 22 kg pro capite, il dato più alto dell’ultimo decennio. Ottimo anche l’andamento del comparto uova, con consumi in aumento del +3,8% e 218 uova pro capite, un indice di penetrazione domestica del 94% e vendite in forte crescita anche nel primo semestre 2025.
Si tratta di risultati che premiano un modello produttivo integrato ed efficiente, capace di rispondere alle sfide del mercato con qualità, trasparenza e capacità di adattamento.Ma i numeri da soli non bastano. Come ha sottolineato il presidente di Unaitalia Forlini, servono strumenti concreti per tutelare la competitività del settore, a partire da una gestione efficace delle minacce sanitarie, prima fra tutte l’influenza aviaria, e da una strategia comune per affrontare la concorrenza di prodotti esteri a basso costo e standard più bassi. La parola chiave è reciprocità, nei controlli, negli accordi e nelle regole di mercato.
L’avicoltura italiana è un presidio strategico di autosufficienza alimentare: proteggerla e accompagnarne l’evoluzione significa investire nel futuro del nostro sistema agroalimentare.
➤ Marianna Caterino

DICEMBRE 2025

4 6 10 16 20
ATTUALITÀ
PRIMO PIANO
Ovomont: tra tradizione e futuro
REPORTAGE
AVEC conclude la 67ª Assemblea Generale a Copenaghen: il settore avicolo europeo sollecita commercio equo, semplificazione e sostegno alle nuove generazioni
INTERVISTA
Pay-per-use: la nuova frontiera dell’automazione avicola
DOSSIER
Broilernet e il futuro del pollo a lenta crescita in Europa: benessere animale, sostenibilità e sfide economiche
30
38
MARKETING
L’industria avicola statunitense sotto pressione: un decennio turbolento. Parte I – Il settore delle uova
NUTRIZIONE
Quando l’apporto proteico è eccessivo?
42 44 48
TRASFORMAZIONE
Salvaguardia della resa produttiva nell’intero processo primario
MARKET
ASSEMBLEA ANNUALE
DI UNAITALIA A ROMA:
LE CARNI BIANCHE SI CONFERMANO
LE PREFERITE DAGLI ITALIANI
Forlini: “Serve una strategia condivisa, strumenti concreti e reciprocità per tutelare competitività e autosufficienza. Bene l’istituzione del tavolo di filiera”.
Cresce l’avicoltura italiana nel 2024: la filiera delle carni bianche registra una crescita della produzione pari al +3,6% in volume e i consumi interni aumentano del +3,7%, raggiungendo i 22 kg pro capite, il valore più alto dell’ultimo decennio. Nel primo semestre 2025 la tendenza si conferma, con una produzione stabile e una spesa domestica in aumento.
A fornire il quadro a Roma il 29 ottobre, nel corso della sua assemblea nazionale, è Unaitalia, l’associazione nazionale del settore avicolo italiano, comparto che conta oggi 64.000 addetti lungo l’intera filiera – di cui 25.500 nella trasformazione – e un fatturato complessivo di 7,75 miliardi di euro (+3,3% sul 2023). Le carni bianche rappresentano il 44% delle carni acquistate dagli italiani e il 34% della spesa domestica complessiva per la carne, confermandosi proteine accessibili, versatili e sostenibili.
Buone le performance anche nel comparto delle uova: +3% la produzione e +3,8% i consumi nel 2024, pari a 218 uova pro capite. L’indice di penetrazione domestica tocca il 94%, il più alto tra le fonti proteiche di origine animale. Un’affezione che si riflette nei dati del primo semestre con crescite del 10% a volume nelle vendite in GDO e dettaglio.

Assemblea annuale Unaitalia
Secondo i dati Ismea 2025, tra tutti i prodotti proteici di origine animale, le carni bianche e le uova hanno registrato la crescita più significativa nei volumi acquistati dalle famiglie dal 2021 al 2024 (+11,8% e +9,7%).
Per il ministro dell’Agricoltura, della Sovranità Alimentare e delle Foreste, Francesco Lollobrigida: “Il settore agricolo e cunicolo ci rende orgogliosi perché risponde appieno alle caratteristiche della sovranità alimentare, garantendo una produzione che copre il consumo nazionale e alimenta l’export, soprattutto a livello europeo, con una bilancia
commerciale positiva, in crescita del +5,36% nel 2024. Per questo, il nostro Governo intende proteggere e valorizzare questo settore, supportando gli imprenditori che hanno saputo esprimere capacità di produzione e qualità superiori rispetto al resto del mondo. In ambito internazionale, chiediamo all’Europa di tutelare la qualità e proteggere le nostre filiere di eccellenza”.
“Il settore avicolo italiano conferma la propria solidità nonostante le incertezze e i timori legati a un contesto
geopolitico e di mercato incerto e sfidante, un quadro regolatorio europeo in evoluzione e le preoccupazioni connesse alla diffusione del virus dell’influenza aviaria in Europa - afferma Antonio Forlini, presidente di Unaitalia. “Vantiamo un modello integrato di filiera che unisce efficienza, dinamicità e una capacità di evolversi e ampliare l’offerta, cogliendo le nuove esigenze del mercato e dei consumatori. Quest’anno celebriamo i 20 anni del Disciplinare di etichettatura delle carni avicole di Unaitalia, un asset strategico del settore che fotografa chiaramente questa realtà, assicurando tracciabilità e coerenza delle informazioni volontarie riportate in etichetta lungo tutta la filiera. Il 76% della produzione nazionale aderisce oggi al disciplinare Unaitalia - prosegue Forlini - e un terzo della produzione italiana certifica nel 2024 parametri di benessere animale in allevamento superiori ai limiti di legge, tra cui utilizzo di arricchimenti ambientali (61%), luce naturale (66%), densità ridotte (33%) e genotipi a più lento accrescimento (8,5%), tutti parametri che esprimono una tendenza in costante progressiva crescita di anno in anno”. Il percorso certificato dal Disciplinare non è frutto di imposizioni ideologiche ma di una scelta lungimirante del settore. Incardinato in una regola tecnica autorizzata dal Ministero dell’Agricoltura nel 2005 e sottoposto ad audit periodici di un organismo terzo di controllo (il CSQA), il Disciplinare - giunto oggi alla sua ottava revisione - è una sintesi della visione dell’avicoltura: la ricerca del punto di equilibrio migliore possibile tra sostenibilità, accessibilità e competitività. “Il settore garantisce un’offerta diversificata di qualità che tiene conto delle scelte reali dei consumatori, non dismettendo mai l’obiettivo di miglioramento continuo di standard e processi lungo tutta la filiera - prosegue Forlini. L’Associazione è al fianco delle imprese fornendo supporto nella analisi dei fabbisogni e la realizzazione di iniziative concrete di formazione, ricerca e condivisione di buone pratiche. Un esempio tangibile di questa visione è la riduzione dell’utilizzo del farmaco antibiotico in avicoltura che dal 2011 al 2024 è stata pari al -95% (fonte: elaborazione Unaitalia su dati ClassyFarm) e prende le mosse da un piano volontario promosso da Unaitalia dieci anni fa.
Per garantire la tenuta dell’unico settore zootecnico 100% made Italy che nel 2024 ha un tasso di autoapprovvigionamento superiore al 105%, l’Associazione chiede una strategia condivisa con le istituzioni che assicuri condizioni eque di concorrenza rispetto ai grandi competitor mondiali e strumenti concreti per sostenerne tenuta e competitività. Tra le priorità indicate:
• reciprocità negli accordi commerciali internazionali, in particolare per gli scambi con il Brasile (Mercosur), la Tailandia e l’Ucraina, da assicurare non solo in termini di principio ma con controlli periodici presso i Paesi esportatori e meccanismi automatici di salvaguardia del mercato UE in caso di turbative;
• indicazione obbligatoria dell’origine della carne anche nei canali Ho.Re.Ca. e sulle piattaforme online, per garantire trasparenza e parità di tutela ai consumatori anche nel
segmento di consumo “fuori casa” che rappresenta una parte rilevante e in crescita del mercato;
• uno sforzo comune nella prevenzione e gestione dell’influenza aviaria attraverso l’individuazione delle risorse per rendere operativo il piano strategico nazionale di gestione del territorio e gli interventi a sostegno della vaccinazione delle specie a più alto rischio, unitamente alla individuazione di strumenti rapidi per l’erogazione degli indennizzi per i danni indiretti legati ai provvedimenti restrittivi delle autorità sanitarie.
“Ribadiremo le nostre richieste al tavolo di filiera avicolo istituito di recente, in accoglimento delle istanze del settore, presso il Ministero dell’Agricoltura e della Sovranità alimentare. L’avicoltura italiana – conclude Forlini –continuerà con impegno a fare la sua parte, collaborando con tutti gli stakeholder per creare le migliori condizioni che la rendano sempre più competitiva e sostenibile”.
Fonte: Unaitalia

Antonio Forlini, Presidente Unaitalia
OVOMONT: TRA TRADIZIONE E FUTURO
Zootecnica in visita all’azienda avicola di Castelvetere sul Calore, dove Rodolfo Bimonte da oltre quarant’anni produce uova con passione, responsabilità e attenzione all’ambiente.

Nel cuore verde dell’Irpinia, tra le colline di Castelvetere sul Calore (Avellino), sorge Ovomont, un’azienda che da più di quarant’anni rappresenta un punto di riferimento nella produzione di uova fresche in Campania. Fondata nel 1980 da Rodolfo Bimonte, dopo una lunga esperienza nella commercializzazione delle uova, l’azienda nasce dal desiderio di offrire ai clienti un prodotto genuino, sicuro e proveniente da un allevamento locale.
Oggi a portare avanti quella visione sono Rodolfo Bimonte e i figli Ettore e Daniela, che con la stessa passione continuano a investire in innovazione e sostenibilità, mantenendo saldi i valori che hanno guidato la famiglia fin dagli inizi.
ZOOTECNICA ◆ Dicembre 2025
Dalle origini alla modernizzazione
Negli anni Ottanta la produzione iniziò con un piccolo allevamento di galline ovaiole. Con il tempo, grazie alla dedizione e alla capacità di rinnovarsi, l’azienda si è ampliata e, agli inizi degli anni Novanta, si è trasferita nell’attuale sito produttivo, dove oggi sorgono due capannoni di allevamento, un centro imballaggio e una terza struttura, in passato destinata alla trasformazione della pollina in concime organico. Per oltre vent’anni, infatti, Ovomont ha gestito internamente la trasformazione del concime organico, vendendolo anche al di fuori della regione. Oggi, nell’ottica
Sede di Ovomont
di un’economia più circolare e sostenibile, le deiezioni vengono invece conferite in un impianto di biogas, dove sono trasformate in energia rinnovabile: un chiaro esempio di come l’azienda abbia saputo evolversi riducendo l’impatto ambientale delle proprie attività.
Produzione e gestione
Attualmente Ovomont alleva 22.704 galline ovaiole in gabbie arricchite, complete di posatoi, grattatoi e aree per il bagno di sabbia, nel pieno rispetto delle normative sul benessere animale. Le linee genetiche vengono periodicamente cambiate in base alle esigenze produttive e di mercato. Le uova vengono raccolte quotidianamente in modo automatico tramite nastri trasportatori, selezionate, calibrate per peso e imballate in confezioni, oppure in vassoi destinati al canale Horeca. Il centro di imballaggio interno garantisce un controllo diretto sulla tracciabilità: ogni uovo è timbrato e ogni confezione riporta il lotto di produzione, consentendo di risalire in tempo reale al ciclo di origine.
Le consegne avvengono con mezzi propri: “I nostri furgoni
partono ogni mattina – racconta Daniela – e nel giro di 24 ore le uova arrivano al cliente finale”.
La distribuzione copre la provincia di Avellino, parte di Benevento e Napoli, affiancando la vendita diretta ai rapporti con grossisti e piccole realtà commerciali.
Energia pulita e materiali riciclabili
L’attenzione all’ambiente è uno dei tratti distintivi di Ovomont. L’azienda ha installato un impianto fotovoltaico da 86 kW grazie al programma Parco Agrisolare, che contribuisce in modo significativo al risparmio energetico e alla riduzione delle emissioni di CO₂.
Anche il packaging rispecchia questa filosofia: le confezioni sono realizzate in carta riciclata, oppure in PET 100% riciclabile, per le quali l’azienda ha ottenuto specifici bonus ambientali.
Grande attenzione è rivolta anche all’uso responsabile dell’acqua, proveniente sia dalla rete idrica sia dai pozzi locali, e alla gestione oculata del mangime, bilanciato in base alle diverse fasi produttive per ridurre gli sprechi e ottimizzare i consumi.
Uno dei furgoni Ovomont in partenza per le consegne giornaliere


Selezionatrice uova
Innovazione e controllo digitale
La gestione dell’allevamento è completamente automatizzata e monitorata da remoto tramite sistemi PLC, che permettono di controllare temperatura, ventilazione, consumo idrico e alimentare.
“Questo ci consente – spiega Ettore – di intervenire tempestivamente in caso di anomalie. Se le galline non depongono come previsto, capiamo subito cosa non va.”
Le uova prodotte sono antibiotic free, a testimonianza di un approccio che privilegia la prevenzione, l’igiene e il rispetto del benessere animale.
Progetti e prospettive
Guardando al futuro, la famiglia Bimonte punta a un ulteriore passo avanti: l’introduzione delle voliere nel secondo capannone, per diversificare la produzione e rispondere alle nuove esigenze del mercato e dei consumatori. “Abbiamo già predisposto gli spazi – racconta Ettore – e il prossimo investimento sarà proprio in questa direzione. Siamo alla terza generazione e vogliamo continuare a crescere, ma senza snaturare la nostra identità.”

Rodolfo Bimonte, fondatore dell’azienda
Un periodo favorevole per il mercato
Oggi, come conferma la famiglia, il mercato delle uova vive una fase positiva: “Il prezzo delle uova è salito, – spiega Rodolfo – mentre il costo dei mangimi si è stabilizzato. In più, la nostra posizione geografica ci tutela: qui in montagna non c’è densità di allevamenti, quindi anche il rischio di influenza aviaria è ridotto”. Una tranquillità meritata, frutto di un’attenzione costante alla biosicurezza e all’aggiornamento delle pratiche aziendali.
Conclusione
Tra tradizione e innovazione, Ovomont rappresenta un esempio virtuoso di impresa familiare italiana capace di coniugare qualità, sostenibilità e radicamento territoriale. Un modello di produzione responsabile che guarda al futuro senza dimenticare le proprie origini, continuando ogni giorno a consegnare uova fresche e genuine, nel pieno rispetto dell’ambiente e del benessere animale.



La selezionatrice in azione
Le uova selezionate e confezionate nel centro imballaggio Ovomont
AVEC CONCLUDE LA 67ª ASSEMBLEA GENERALE
A COPENAGHEN: IL SETTORE AVICOLO EUROPEO
SOLLECITA COMMERCIO EQUO, SEMPLIFICAZIONE E SOSTEGNO ALLE NUOVE GENERAZIONI
AVEC, l’Associazione dei trasformatori e commercianti di pollame dell’UE, ha concluso il 7 settembre la sua 67ª Assemblea Generale ospitata dal Consiglio danese per l’Agricoltura e l’Alimentazione a Copenaghen. La conferenza di quest’anno, dal tema “Competitività in un mondo che cambia”, si è concentrata sulla resilienza agroalimentare europea e sul ruolo del settore avicolo dell’UE nel garantire una crescita sostenibile e la sicurezza alimentare per il futuro.
“Il nostro settore è una delle storie di successo silenziose d’Europa: efficiente, sostenibile e realmente circolare. Offriamo una proteina di alta qualità con la più bassa impronta di carbonio tra le carni, utilizzando ogni parte del pollo nell’alimentazione, nella farmaceutica, nella nutrizione animale, nei fertilizzanti e nell’energia” ha dichiarato il presidente di AVEC, Gert-Jan Oplaat. “Questo rende il pollame indispensabile per la sicurezza alimentare europea.” Nonostante questi punti di forza, il settore è sottoposto a crescenti pressioni. Le importazioni di pollame da Paesi terzi come Brasile, Cina e Ucraina continuano ad aumentare, spesso prodotte in condizioni che non sarebbero mai autorizzate nell’UE – “il 25% del petto di pollo consumato nell’UE proviene ormai da Paesi terzi” ha sottolineato Oplaat.
Come se non bastasse, vi è anche un grave divario demografico: “Solo il 6,5% degli agricoltori dell’UE ha meno di 35 anni e appena l’11,9% meno di 40” ha dichiarato Sébastien Pérel di CEJA, ricordando che “senza giovani agricoltori non ci sarà alcun futuro per l’agricoltura”. Si è discusso anche dell’accordo MERCOSUR, visto come una minaccia poiché continua a non rispettare il modello europeo di sostenibilità e rischia di creare concorrenza sleale. “I nostri standard, i nostri sforzi per la sostenibilità e la fiducia dei consumatori europei non devono essere sacrificati”, ha ribadito Oplaat. “Il Consiglio e il Parlamento europeo dovrebbero respingere questa proposta e difendere l’agricoltura europea.”
Guardando al futuro
Guardando avanti, nel nuovo rapporto dell’UE Vision for Agriculture and Food, la sicurezza alimentare e il commercio equo sono priorità assolute. “Siamo (riferendosi al settore avicolo europeo e alla Commissione) molto più allineati rispetto al passato” ha confermato Catherine Geslain-Lanéelle, direttrice presso la DG AGRI della Commissione europea. AVEC considera ciò come la base per una cooperazione più solida negli anni a venire: “Più ci impegniamo in un dialogo basato su dati concreti e in partenariati, meglio potremo garantire una competitività sostenibile a vantaggio dei cittadini europei, degli agricoltori e dell’ambiente” ha dichiarato la segretaria generale di AVEC, Birthe Steenberg.
Per rafforzare con dati concreti questa nuova direzione strategica verso la competitività, AVEC ha annunciato che pubblicherà un nuovo Competitiveness Study all’inizio del 2026. Basato sui dati dei costi del 2024, lo studio quantificherà l’impatto della legislazione UE, valuterà la competitività rispetto ai produttori extra-UE e modellerà scenari di politica commerciale. “Il nuovo studio mira a fornire ai decisori politici le prove necessarie per garantire che gli elevati standard europei restino un punto di forza, non un handicap” ha aggiunto Steenberg.
Dall’Assemblea Generale di Copenaghen è emerso quindi un messaggio chiaro e urgente ai decisori politici: le regole e la burocrazia devono essere semplificate, i produttori europei devono essere protetti dalla concorrenza sleale e

▲ Figura 1 – Importazioni di carne di pollame nell’UE
Fonte: DG Agri.
occorre sostenere l’innovazione e il ricambio generazionale. “Possiamo e vogliamo rimanere competitivi,” ha concluso Oplaat “ma abbiamo bisogno che l’Europa stia al nostro fianco. Senza reciprocità negli scambi e condizioni eque in patria, l’Europa rischia di esternalizzare la propria sicurezza alimentare.”
In concomitanza con l’Assemblea Generale, AVEC ha pubblicato il suo 2025 Annual Report, che fornisce un’analisi completa delle priorità, delle sfide e dei risultati del settore avicolo europeo nell’ultimo anno. Il rapporto illustra anche gli obiettivi strategici futuri dell’associazione.
2025 Annual Report
Vediamo cosa dicono le statistiche del rapporto annuale del 2025.
Innanzitutto, nel 2024 in UE è aumentata la produzione di pollame rispetto agli anni passati, attestandosi su 13.925 migliaia di tonnellate peso carcassa, contro le 13.393 del 2023. In aumento rispetto agli anni precedenti sono anche consumo (12.281) e consumo pro capite (25,1 kg a testa). L’autosufficienza rimane stazionaria al 108%, mentre le importazioni rispetto all’anno precedente diminuiscono di 4 punti.

Come nel 2023, anche nel 2024 sul podio della maggiore produzione si trovano Polonia, UK e Francia. Mentre Polonia e Francia sono in aumento rispetto agli anni passati, la produzione dell’UK subisce una leggera flessione rispetto al 2023. (Tabella 1)
Guardando invece alla produzione di carne di pollame nel resto del mondo, di 140.621 tonnellate, in aumento rispetto al 2023, al primo posto si trova la Cina, seguita da Usa e Brasile, tutti e tre in aumento rispetto all’anno precedente (Tabella 2).
Passiamo ora alle importazioni e alle esportazioni. In UE i maggior importatori di carne di pollame sono Paesi Bassi e Germania, entrambi in diminuzione rispetto all’anno precedente, e Francia, in leggero aumento (Tabella 3).
Per quanto riguarda le esportazioni, invece, Polonia, Paesi Bassi e Belgio/ Lussemburgo si attestano sul podio, proprio come l’anno precedente ( Tabella 4 ).
I prodotti più importati sono carne di pollame salata in salamoia, carne di pollo congelata e carne di pollo fresca; i più esportati carne di pollo congelata, carne di pollo fresca e preparazioni a base di pollame.
■ Tabella 1 – Produzione interna lorda di carne di pollame nell’UE e nel Regno
Unito (’000 tonnellate peso carcassa)
Nota: dati parziali, provvisori o stimati. Per i Paesi UE vi sono alcune differenze significative tra i dati nazionali e quelli EUROSTAT. Le righe sono state in parte riviste, poiché Eurostat non continua più a fornire i bilanci di approvvigionamento.
Ora i dati si basano maggiormente su altre fonti e su calcoli propri.
Fonti: MEG secondo Commissione europea, dati nazionali, FAO ed EUROSTAT.

Nel resto del mondo, Giappone, Arabia Saudita e Iraq sono i maggiori importatori di polli da carne (tutti e tre in aumento rispetto all’anno precedente, mentre, gli esportatori maggiori sono Brasile, Usa e Tailandia. Il report AVEC, come di consueto, analizza anche i consumi pro-capite. Come l’anno precedente, i primi tre posti sono occupati da Portogallo, Irlanda e Polonia.
Prospettive future
Dopo un’attenta analisi del mercato di pollame in dettaglio, il rapporto AVEC traccia anche le prospettive future, spingendosi fino al 2035, pronosticando che in tale anno ben 9 indicatori si attesteranno sul segno + (Tabella 5).
Si tratta di:
• Produzione interna lorda
• Importazioni
• Esportazioni
• Commercio netto
• Uso domestico
■ Tabella 2 – Produzione di carne avicola nei Paesi terzi (’000 tonnellate peso carcassa)
Nota: dati parziali provvisori o stimati. Prevalentemente produzione interna lorda. *) Solo carne di pollo e tacchino. Fonti: MEG su dati USDA, FAO e dati nazionali.

• Consumo pro capite kg rw.e. (r.w.e. = peso equivalente al dettaglio)
• Prezzo di mercato UE (EUR/t)
• Prezzo di mercato mondiale (EUR/t)
• Prezzo di mercato mondiale (USD/t)
Fonte:https://avec-poultry.eu/wp-content/ uploads/2025/08/07394-AVEC-annual-report-2025.pdf
■ Tabella 3 – Importazioni dei Paesi UE di carne avicola (’000 tonnellate peso carcassa)
Nota: 1) Esclusi preparati, fegati, carne salata e pollame vivo. – Dati 2019 in parte preliminari. – I dati nelle statistiche commerciali e nei bilanci commerciali EUROSTAT presentano alcune differenze.
Fonti: MEG su Eurostat e statistiche nazionali.


■ Tabella 4 – Esportazioni dei Paesi UE di carne avicola (’000 tonnellate peso carcassa)
Nota: 1) Esclusi preparati, fegati e carne salata. Fonte: MEG su Eurostat e statistiche nazionali.


■ Tabella 5 – Bilancio della carne avicola UE, 2005–2035 (’000 tonnellate equivalenti peso carcassa)
* r.w.e. = equivalente peso vendita al dettaglio. I coefficienti per trasformare il peso carcassa in peso vendita al dettaglio sono 0,7 per bovini e vitelli, 0,78 per suini e 0,88 sia per carne avicola sia per carne ovina e caprina. Fonte: https://agriculture.ec.europa.eu/data-and-analysis/markets/outlook/medium-term_en
ZOOTECNICA ◆ Dicembre 2025
14

PAY-PER-USE:
LA NUOVA FRONTIERA
DELL’AUTOMAZIONE AVICOLA

Questo mese Vencomatic risponde alle nostre domande sul suo nuovo modello di automazione basato sul pay-per-use, pensato per allineare i costi alla produttività e rendere accessibili tecnologie avanzate senza l’onere di un ingente investimento iniziale.

Perché gli allevatori di ovaiole dovrebbero prendere in considerazione l’automazione del processo di movimentazione delle uova?
La raccolta e la movimentazione manuale delle uova richiede molto tempo, è laboriosa e aumenta il rischio di rotture e contaminazioni. L’automazione non solo migliora l’efficienza, ma salvaguarda anche la qualità delle uova, garantendo un prezzo migliore sul mercato e clienti più soddisfatti.
Cosa distingue la soluzione di Vencomatic dai sistemi automatizzati tradizionali?
A differenza dei sistemi tradizionali, che richiedono un ingente investimento iniziale, la soluzione di Vencomatic funziona con un modello pay-per-use. Ciò significa che gli allevatori possono iniziare con un investimento ridotto e pagare solo quando il sistema è in funzione e genera valore per la loro attività.
In che modo il modello pay-per-use avvantaggia gli allevatori di piccole e medie dimensioni?
Elimina la barriera degli elevati costi di capitale. Gli allevatori non devono più impegnare ingenti somme di denaro in anticipo. Possono invece accedere a una tecnologia di livello mondiale e pagare solo ciò che utilizzano, rendendo più facile espandere le loro attività in modo sostenibile.
L’automazione significa che gli agricoltori perderanno il controllo delle loro attività?
Assolutamente no. Le attrezzature Vencomatic sono progettate per integrarsi perfettamente nelle pratiche agricole esistenti. Gli agricoltori mantengono il pieno controllo, ma il sistema riduce il lavoro fisico, migliora l’affidabilità e fornisce informazioni in tempo reale per aiutarli a prendere decisioni migliori.
In quanto tempo un allevatore può vedere i vantaggi del sistema Vencomatic?
L’impatto è quasi immediato. Gli allevatori notano una riduzione delle uova rotte o sporche, una diminuzione dei costi di manodopera e un aumento della produttività subito dopo l’installazione. Nel tempo, il sistema si ripaga da solo riducendo le perdite e massimizzando l’efficienza.
Questo sistema è destinato solo alle grandi aziende agricole commerciali?
No. Il modello pay-per-use è stato progettato per rendere la tecnologia avanzata accessibile alle aziende agricole di tutte le dimensioni. Che tu gestisca una piccola azienda agricola a conduzione familiare con 20.000 galline o un’attività commerciale in espansione, il modello ti garantisce di pagare solo in proporzione al tuo utilizzo.

Qual è il requisito minimo di produzione per il payper-use?
E per quanto riguarda la manutenzione e l’assistenza?
Vencomatic offre pacchetti completi di assistenza e servizi. Poiché il sistema è a pagamento in base all’utilizzo, mantenerlo efficiente è anche nell’interesse di Vencomatic, che garantisce agli allevatori una soluzione affidabile su cui poter contare.
In che modo investire nella gestione automatizzata delle uova aiuta a far crescere l’attività di un allevatore?
Migliorando l’efficienza, riducendo le perdite e garantendo una maggiore qualità delle uova, gli allevatori possono aumentare la redditività. L’automazione libera anche tempo e risorse di manodopera, consentendo agli allevatori di concentrarsi sull’espansione del proprio allevamento, sul miglioramento del benessere degli animali o sull’esplorazione di nuove opportunità di mercato.
In che modo il modello pay-per-use differisce dal leasing delle attrezzature?
Il leasing richiede pagamenti mensili fissi indipendentemente dall’utilizzo del sistema, il che significa che gli allevatori pagano anche nei periodi di bassa produzione. Con il modello pay-per-use di Vencomatic, gli allevatori pagano solo quando il loro sistema è in funzione e produce uova. Questo approccio allinea i costi direttamente alla produttività, offrendo flessibilità e tranquillità finanziaria, soprattutto in un mercato in cui la domanda e la produzione possono subire fluttuazioni.
Per poter beneficiare del modello pay-per-use di Vencomatic, un allevamento deve ospitare almeno 20.000 galline. Ciò garantisce che il sistema funzioni a un livello di efficienza ottimale e offra un forte ritorno sull’investimento. Per gli allevamenti che soddisfano o superano questa soglia, il pay-per-use offre un modo scalabile ed economico per automatizzare la gestione delle uova senza costi iniziali elevati.
Quale modello Vencomatic disponibile con il pay-peruse consigliereste maggiormente alle aziende avicole di piccole e medie dimensioni?
Il modello pay-per-use di Vencomatic offre alle aziende agricole l’accesso a soluzioni di automazione avanzate senza l’onere di un ingente investimento iniziale. Tra le opzioni più interessanti per i produttori di piccole e medie dimensioni vi sono Prinzen 70, Meggsius Count e Meggsius Connect. La Prinzen 70 è una macchina confezionatrice di uova compatta e ad alte prestazioni che lavora fino a 25.200 uova all’ora con estrema cura. La sua precisione garantisce che oltre il 99,7% delle uova venga posizionato con la punta rivolta verso il basso, riducendo le rotture e massimizzando la resa vendibile, il tutto con un ingombro adatto alle operazioni di piccole dimensioni.
Il sistema Meggsius Count utilizza una tecnologia avanzata di telecamere per contare con precisione le uova su singoli nastri trasportatori, anche in condizioni difficili come scarsa illuminazione o presenza di polvere. Ciò fornisce agli allevatori dati di produzione precisi e in tempo reale che supportano decisioni di gestione migliori.

Infine, Meggsius Connect porta l’integrazione digitale nella stalla. Raccogliendo e visualizzando i dati di produzione da tutti i sistemi collegati, consente agli agricoltori di monitorare le prestazioni, identificare le tendenze e reagire rapidamente a qualsiasi cambiamento, da qualsiasi luogo e in qualsiasi momento.
Insieme, queste tecnologie offrono alle aziende agricole di piccole e medie dimensioni un percorso pratico e scalabile verso l’automazione professionale. Con il modello pay-peruse, gli agricoltori pagano solo quando i loro sistemi sono in funzione, allineando i costi direttamente alla produttività ed eliminando i pagamenti mensili fissi associati ai modelli di leasing tradizionali.
Qual è il ruolo di Meggsius Connect nel modello payper-use?
Uno dei vantaggi più significativi del modello pay-peruse di Vencomatic è che può includere un abbonamento a Meggsius Connect come parte del pacchetto.
Meggsius Connect è una potente piattaforma digitale che raccoglie dati in tempo reale da tutti i sistemi collegati nell’azienda agricola, come la raccolta, il conteggio e
il confezionamento delle uova, e li presenta attraverso un’intuitiva dashboard online. Gli allevatori ottengono una visibilità in tempo reale sul flusso delle uova, sulle prestazioni del pollame e sull’efficienza del sistema, accessibile da qualsiasi dispositivo e ovunque. Includendo Meggsius Connect nel modello pay-per-use, Vencomatic garantisce agli allevatori non solo i vantaggi dell’automazione, ma anche una visione digitale continua. Questa integrazione consente un processo decisionale proattivo, l’individuazione tempestiva dei problemi e una maggiore produttività, il tutto senza costi di abbonamento aggiuntivi.

Scansiona il codice QR per ulteriori informazioni

BROILERNET E IL FUTURO DEL POLLO
A LENTA CRESCITA IN EUROPA: BENESSERE ANIMALE, SOSTENIBILITÀ E SFIDE ECONOMICHE
Il settore europeo di produzione del pollo da carne si trova a un bivio: da un lato, la necessità di efficienza dettata dalla crescente domanda di proteine animali; dall’altro, la pressione normativa e dei consumatori per una transizione verso pratiche più sostenibili e un miglior benessere animale. In questo contesto, le razze di pollo a lenta crescita rappresentano un’alternativa promettente se applicate a modelli sostenibili su larga scala che integrino le implicazioni economiche con le strategie per contenere l’impatto ambientale. Il successo del settore dipende dall’integrazione di scienza, mercato e comunicazione.
➤ Annunziata Palamara e Paolo Ferrari
CRPA – Centro Ricerche Produzioni Animali, Reggio Emilia
Balla di paglia per arricchimento ambientale
Fonte: Wageningen Livestock Research.

Innovazione e nuove sfide per la filiera avicola europea
Il settore europeo di produzione del pollo da carne si trova oggi a un bivio. Da una parte, la domanda crescente di proteine animali spinge verso sistemi produttivi sempre più efficienti; dall’altra, normative, pressioni ambientali e aspettative dei consumatori impongono una transizione verso pratiche più sostenibili e rispettose del benessere animale.
In Italia e in molti altri Paesi europei, gli allevamenti intensivi tradizionali sono spesso associati a elevati consumi di risorse ed emissioni di gas a effetto serra, oltre a sollevare preoccupazioni sul benessere animale e sulla qualità della carne. È interessante notare, però, che i sistemi di produzione del pollo da carne sono tra i meno impattanti tra i sistemi zootecnici in termini di emissioni di gas serra (de Vries e de Boer, 2010; Poore e Nemecek, 2018), pur contribuendo significativamente alle emissioni di azoto e fosforo, che possono causare fenomeni di acidificazione ed eutrofizzazione. Nell’Unione Europea, si stima che i sistemi avicoli, insieme a quelli suini, producano circa l’85% delle emissioni totali di ammoniaca.
In questo contesto, diventa cruciale individuare strategie che riducano l’impatto ambientale, migliorino il benessere degli animali e rispondano alle richieste dei consumatori. Le razze di pollo a lenta crescita rappresentano un’alternativa promettente: pur richiedendo tempi di crescita più lunghi, offrono vantaggi significativi in termini di benessere animale e di qualità della carne, seppur comportando nuove sfide nella gestione delle risorse.
La rete tematica europea BroilerNet
La rete tematica BroilerNet per l’innovazione nella produzione del pollo da carne (https://broilernet.eu) coinvolge allevatori, ricercatori, veterinari e consulenti di 13 Paesi europei. L’iniziativa, finanziata dal programma di ricerca e innovazione Horizon Europe, mira a migliorare la resilienza e la sostenibilità del settore europeo dei polli da carne creando uno spazio di interazione tra scienza e pratica e favorendo la co-creazione di migliori pratiche innovative pronte all’uso negli allevamenti di polli da carne in Europa.

Partner italiani del progetto sono il CRPA di Reggio Emilia (leader del pacchetto di lavoro (WP) sulla sostenibilità ambientale) e Unaitalia.
BroilerNet ha raccolto e valutato la fattibilità di buone pratiche innovative e di soluzioni di ricerca pronte per essere messe in pratica che rispondono alle esigenze più urgenti di innovazione nei tre temi chiave: sostenibilità ambientale, benessere animale e gestione sanitaria. L’utilizzo di razze di polli a lenta crescita è una delle principali sfide che il settore avicolo si trova ad affrontare oggi, come emerso anche dalla consultazione delle associazioni allevatori nei Paesi partner di BroilerNet. L’uso di queste razze è previsto dalla normativa europea per l’allevamento biologico e raccomandato nell’allevamento free-range.
Sul tema dell’impiego di razze a lento accrescimento, Ingrid de Jong e Jamie Kater di Wageningen Livestock Research hanno organizzato un workshop nell’ambito del progetto BroilerNet, tenutosi il 15 novembre 2024 a Hannover (Germania), in occasione della fiera internazionale EuroTier. L’iniziativa ha rappresentato un importante momento di confronto tra ricercatori, allevatori e operatori del settore, con l’obiettivo di individuare i principali fabbisogni di innovazione e condividere buone pratiche utili a garantire la sostenibilità dei sistemi produttivi basati su ceppi di pollo a crescita più lenta.
Durante l’incontro sono emerse numerose esigenze prioritarie. Tra queste, la necessità di definire in modo chiaro il limite massimo di accrescimento e di stabilire metriche condivise per valutare i benefici di benessere animale associati alle diverse linee genetiche. È stato inoltre sottolineato il bisogno di strumenti e indicatori comuni per confrontare la sostenibilità dei vari sistemi di produzione e di procedure di audit affidabili per la certificazione del pollo a lenta crescita.
Un altro tema centrale ha riguardato la progettazione degli arricchimenti ambientali e degli spazi esterni — come le verande o “giardini d’inverno” — per gli allevamenti biologici e all’aperto, insieme all’ottimizzazione della ventilazione e del riscaldamento negli allevamenti a bassa densità. I partecipanti hanno inoltre evidenziato la necessità di programmi di vaccinazione adeguati alle razze a lenta crescita e di misure di biosicurezza rafforzate, da mantenere più a lungo nei contesti outdoor, dove è maggiore il rischio di contatto con uccelli migratori o predatori.
Dal punto di vista nutrizionale, è stato ribadito che le razze a lenta crescita richiedono programmi alimentari specifici, in grado di garantire una crescita graduale ma regolare, preservando la salute di ossa, muscoli e sistema immunitario. Sul piano gestionale ed economico, invece, sono stati messi in evidenza l’incertezza finanziaria, i rischi di investimento e la competizione con le carni d’importazione, che possono ostacolare l’adozione su larga scala di questi sistemi produttivi.
Logo progetto BroilerNet

Un aspetto altrettanto importante riguarda la comunicazione verso i consumatori. I partecipanti hanno sottolineato la necessità di educare il pubblico sui valori e gli attributi di sostenibilità legati alla carne di pollo proveniente da razze a lenta crescita, utilizzando i dati di filiera per valorizzare il prodotto in fase di commercializzazione e differenziarlo da quello convenzionale.
Per affrontare le sfide più rilevanti, il workshop ha proposto diverse buone pratiche, tra cui un maggiore investimento nella formazione e nell’aggiornamento del personale su temi come il benessere animale, la biosicurezza e la gestione dei polli in sistemi alternativi. Sul fronte economico, sono stati suggeriti accordi di filiera più equi, capaci di distribuire i margini lungo tutta la catena del valore, e strategie per ridurre i costi mediante l’impiego di ingredienti alternativi per i mangimi o la produzione interna di materie prime — soluzioni che possono anche migliorare l’impronta ambientale complessiva degli allevamenti.
European Chicken Commitment: standard più alti per il benessere
Accanto alle attività di ricerca e sperimentazione promosse da BroilerNet, anche il mercato e le organizzazioni della società civile stanno spingendo verso un’evoluzione del settore. Un ruolo chiave è giocato dall’European Chicken Commitment (ECC), un’iniziativa promossa da oltre 30 organizzazioni per la protezione degli animali e sottoscritta
da più di 300 aziende della GDO e dell’industria alimentare (fonte: Chicken Watch). L’ECC ha stabilito standard di allevamento più restrittivi rispetto a quelli minimi fissati dalla legislazione europea, come l’adozione di razze a lenta crescita, spazi maggiori per gli animali, accesso alla luce naturale, arricchimenti ambientali e metodi di macellazione più rispettosi del benessere. Le razze a lenta crescita riducono problemi di salute tipici delle linee genetiche convenzionali, come malformazioni scheletriche e zoppia, e favoriscono comportamenti naturali come il razzolamento e il bagno di polvere.
Le linee a crescita rapida, invece, mostrano tassi più elevati di scarti post-mortem dovuti a “tecnopatie” come ascite, decolorazione, cellulite, periepatite e miopatie del muscolo pettorale (Barbut, 2020; Baxter et al., 2021; Rayner et al., 2020). Migliorare il benessere può quindi avere effetti positivi anche sull’impatto ambientale, riducendo mortalità e scarti al macello (Kyriazakis et al., 2024).
Pro e contro del pollo a lenta crescita
I vantaggi delle razze a lenta crescita sono evidenti: migliore benessere animale, riduzione di problemi di salute, espressione di comportamenti naturali e carne con caratteristiche organolettiche superiori. Tuttavia, l’utilizzo di queste razze richiede più tempo e risorse per raggiungere il peso di macellazione, aumentando il consumo di mangimi e acqua, così come la produzione di effluenti e le emissioni di azoto e fosforo.
Workshop organizzato all'EuroTier di Hannover per discutere le strategie di allevamento dei polli a lenta crescita
Sul piano economico, i costi più elevati della carne che ne derivano si riflettono sul prezzo finale, il cui aumento ne limita la diffusione senza adeguati incentivi o supporto di mercato. Come riportato nello studio di Sell-Kubiak et al. (2017), la selezione genetica mirata a migliorare l’efficienza alimentare dei broiler ha portato benefici non solo in termini di crescita più veloce e di minore indice di conversione alimentare, ma anche di sostenibilità ambientale, riducendo le emissioni di gas serra.
Per continuare a fare progressi in questo campo, non basta però puntare solo sull’efficienza generale. È fondamentale comprendere anche quali geni influenzano la capacità dei polli di utilizzare al meglio i diversi nutrienti. Alcuni studi hanno dimostrato, per esempio, che selezionare polli in grado di digerire meglio il grano può ridurre fino al 61% le deiezioni solide e fino al 56% quelle liquide, oltre a diminuire l’escrezione di nitrati e fosfati rispettivamente del 13% e del 30% (De Verdal et al., 2011).
Un ruolo decisivo in questo processo è svolto dal microbiota intestinale, ovvero l’insieme dei microrganismi che vivono nell’intestino. Questi batteri sono in grado di riciclare l’azoto scomponendo l’acido urico e di riutilizzare l’ammoniaca trasformandola in proteine batteriche. Entrambi i meccanismi contribuiscono a un uso più sostenibile dei nutrienti nell’allevamento avicolo. Capire meglio come il microbiota interagisce con l’organismo del pollo potrebbe, in futuro, portare a una digestione più efficiente dei mangimi, riducendo ulteriormente i rifiuti e le emissioni di gas serra associate alla produzione di carne avicola.
Impatti ambientali ed economici: i risultati degli studi ECC e WUR
Le valutazioni ambientali confermano questa complessità: diversi studi hanno stimato come l’allevamento a lenta crescita incida sull’impronta di carbonio in misura variabile, a seconda dell’approccio metodologico adottato.
Un recente studio commissionato da ECC e realizzato dalla società di consulenza inglese specializzata in agricoltura ADAS stima che l’adozione degli standard ECC nei sistemi avicoli europei comporterebbe un aumento del 24,4% delle emissioni di gas serra, passando da 6,68 a 8,31 kg CO2e per chilogrammo di carne prodotta. Questo incremento è principalmente dovuto al ciclo di crescita più lungo dei polli a lenta crescita, al maggiore consumo di mangime e alla minore resa in carne rispetto ai broiler convenzionali. In altre parole, servono più tempo e più risorse per ottenere la stessa quantità di prodotto finale, aumentando le emissioni per chilogrammo di carne vendibile.
Una stima più contenuta emerge invece dal Greenwell Project della Wageningen University & Research (WUR), che calcola un aumento medio delle emissioni
di circa 6,3% rispetto ai polli convenzionali. Nel modello olandese, i sistemi a maggiore benessere animale mostrano un’efficienza alimentare leggermente inferiore, ma l’incremento delle emissioni risulta più moderato rispetto allo studio ECC.
La differenza tra i due risultati dipende soprattutto dalle diverse metodologie. L’analisi ECC considera l’impatto per chilogrammo di carne commercializzabile, includendo le fasi post-allevamento come macellazione e lavorazione e tenendo conto della resa minore delle razze a lenta crescita. Al contrario, WUR utilizza come riferimento il chilogrammo di peso vivo fino al macello, senza considerare le perdite post-macello.
Dal punto di vista economico, l’adozione degli standard comporta un significativo aumento dei costi di produzione, stimato da ADAS, su commissione di AVEC (associazione ombrello che riunisce tutte le rappresentanze nazionali del settore avicolo europeo) in circa +37,5% per chilogrammo di carne rispetto al sistema convenzionale. Oltre a questo incremento operativo, per mantenere la produzione di carne di pollo a livello attuale nell’Unione Europea secondo gli standard ECC sarebbe necessario realizzare circa 10.000 nuovi capannoni, con un investimento stimato di 8,243 miliardi di euro, basato su un costo di circa 420 euro per metro quadrato di spazio produttivo.

Presentazione del Friedrich Loeffer Institute a EuroTier sull’uso di polli a lenta crescita
Gli studi condotti da Wageningen University & Research (WUR) nell’ambito del progetto Greenwell confermano un aumento dei costi, ma in misura più contenuta (+19% a livello di allevamento). Tuttavia, il maggior valore di mercato dei prodotti provenienti da sistemi a più alto benessere può compensare parzialmente tali costi, permettendo agli allevatori di mantenere una redditività simile a quella del sistema convenzionale.
Conclusione
Il futuro della produzione di polli da carne in Europa sarà sempre più guidato dalle scelte dei consumatori, una parte dei quali è sensibile ai temi della sostenibilità ma anche al prezzo di mercato, che rimane uno dei principali fattori di acquisto insieme a gusto e sicurezza alimentare (Ferrari, 2024).
L’allevamento di pollo a lento accrescimento può rappresentare una soluzione concreta per conciliare benessere animale e qualità della carne. Riuscire a renderlo sostenibile su larga scala richiede un approccio
integrato, che consideri anche le implicazioni economiche e le strategie per contenere l’impatto ambientale. Solo integrando scienza, mercato e comunicazione il pollo a lento accrescimento potrà diventare un modello di riferimento per un’alimentazione più etica e sostenibile in Europa.
Bibliografia
ADAS. (2024). Costs and implications of the European Chicken Commitment in the EU. European Chicken Commitment. Barbut, S. (2020). Understanding the woody breast syndrome and other myopathies in modern broiler chickens. Proceedings of the Australian Poultry Science Symposium, 99–102. Baxter, M., Richmond, A., Lavery, U., O’Connell, N. E., & Yildirim, A. (2021). A comparison of fast-growing broiler chickens with a slower-growing breed type reared on higher welfare commercial farms. PLOS ONE, 16(11), e0259333. https://doi.org/10.1371/journal.pone.0259333
Bos, B., van Kernebeek, H., Mostert, P., van Harn, J., van Horne, P., & de Jong, I. (2024). Welfare, environmental
impact and economy of broiler chicken production: An overview of the lessons learned from the Greenwell project. Wageningen University & Research.
Clark, M., & Tilman, D. (2017). Comparative analysis of environmental impacts of agricultural production systems, agricultural input efficiency and food choice. Environmental Research Letters, 12(6), 064016. https://doi.org/10.1088/17489326/aa6cd5
De Verdal, H., Narcy, A., Bastianelli, D., Chapuis, H., Même, N., Urvoix, S., Maisonnier, S., Carré, B., & Mignon-Grasteau, S. (2011). Improving the efficiency of feed utilization and reducing the environmental impact of poultry production through genetic selection for digestive efficiency.
Animal, 5(7), 1089–1098. https://pubmed.ncbi. nlm.nih.gov/21733156/
de Vries, M., & de Boer, I. J. M. (2010). Comparing environmental impacts for livestock products: a review of life cycle assessments. Livestock Science, 128(1–3), 1–11. https://doi.org/10.1016/j. livsci.2009.11.007
Ferrari, P. (2024). EU CAP Network Focus Group ’Alternative solutions for livestock product differentiation’. Starting paper. 15 November 2024. EU CAP Network.
Fontanesi, L., Nanni Costa, L., Petracci, M., & Trevisi, P. (2024). Produzioni animali e bioeconomia. In Atti del XX Convegno AISSA — Le scienze agrarie nella bioeconomia (Vol. 5, p. 35). Associazione Italiana delle Società Scientifiche Agrarie.
Kyriazakis, I., Dokou, S., Taylor, J., Giannenas, I., & Murphy, E. (2024). A meta-analysis of the sources of variation in the environmental impacts of different broiler production systems. British Poultry Science, 66(2), 193–205. https://doi.org/ 10.1080/00071668.2024.2409192
Poore, J., & Nemecek, T. (2018). Reducing food’s environmental impacts through producers and consumers. Science, 360(6392), 987–992. https:// doi.org/10.1126/science.aaq0216
Rayner, A. C., Newberry, R. C., Vas, J., & Mullan, S. (2020). Slow-growing broilers are healthier and express more behavioural indicators of positive welfare. Scientific Reports, 10(1), 15151. https:// doi.org/10.1038/s41598-020-72198-x
Sell-Kubiak, E., Wimmers, K., Reyer, H., & Szwaczkowski, T. (2017). Genetic aspects of feed efficiency and reduction of environmental footprint in broilers: a review. Journal of Applied Genetics, 58(4), 487–498. https://doi. org/10.1007/s13353-017-0392-7

3000 collaboratori
Presenza globale in paesi
28 milioni
700 di misurazioni
milioni
500 di valori genetici milioni


Programma di selezione su 8 specie con 14 marchi allevamenti di selezione
di moltiplicazione
di animali nella nostra banca dati
HENDRIX GENETICS PUNTA SU EGGBASE PER UNA
GESTIONE AVANZATA DEI DATI
Hendrix Genetics punta a generare valore in ogni fase della filiera, dal continuo miglioramento genetico delle sue galline ovaiole — in cui è leader nel settore — fino al supporto all’innovazione nei prodotti destinati al consumatore finale. I dati rappresentano il cuore dei suoi programmi di selezione e sviluppo, e la sua attenzione strategica alla loro gestione rafforza ulteriormente l’impegno verso un servizio tecnico globale sempre più efficace per i clienti.
Eggbase Ltd, azienda britannica specializzata in soluzioni digitali per il settore avicolo, offre una suite di software altamente specializzati, sviluppati da un team esperto con competenze uniche nella genetica e nella gestione dei dati. Da oltre dieci anni, Eggbase organizza e analizza dati primari provenienti da allevamenti di ovaiole, riproduttori e polli da carne, fornendo agli allevatori strumenti avanzati per ottimizzare salute, performance ed efficienza, grazie all’analisi integrata di input, ambiente e risultati produttivi.
Il software Eggbase è stato progettato su un’infrastruttura cloud moderna e con una libreria di integrazioni compatibile con le più recenti tecnologie di allevamento, come sensori e controllori di processo. Questo consente una visualizzazione rapida e sicura dei dati raccolti in allevamento, accessibile solo da utenti autorizzati dal proprietario. Il sistema garantisce la protezione dei dati e permette, su richiesta, la condivisione con partner commerciali di fiducia per offrire consulenze tecniche mirate. Eggbase offre anche funzionalità di benchmarking anonimo, qualora il proprietario desideri partecipare. Dopo un’attenta analisi delle soluzioni software disponibili a livello globale, Hendrix Genetics ha identificato Eggbase come una risorsa senza pari per semplificare la raccolta e l’analisi dei dati primari negli allevamenti avicoli.

offrire un supporto tecnico ancora più efficace, basato su dati di produzione aggiornati e affidabili.”
Un legame costruito nel tempo, rafforzato dall’esperienza
“Eggbase svolgerà un ruolo fondamentale nel rafforzare i nostri servizi di assistenza clienti internazionali e, nel lungo periodo, nel potenziare le nostre capacità di ricerca e sviluppo” afferma Gosse Veninga, Direttore della divisione Product Excellence, Layers & Traditional Poultry Business Unit di Hendrix Genetics. “Solo con l’autorizzazione del cliente, Eggbase permetterà ai nostri team regionali di
Hendrix Genetics vanta una collaborazione duratura e articolata con Eggbase Ltd. Fondata nel 2011 da Anne Fleck, Eggbase ha partecipato a numerosi seminari tecnici internazionali organizzati da Hendrix Genetics e ha tenuto presentazioni presso le scuole di formazione di Hendrix Genetics. Le loro piattaforme digitali, Eggsense e Avisense,
sono oggi utilizzate in quasi 1.500 allevamenti avicoli distribuiti su quattro continenti. Tra questi, diversi distributori e produttori commerciali o di riproduttori hanno già adottato i sistemi Eggbase, scegliendo di condividere in modo sicuro i propri dati con Hendrix Genetics. È importante sottolineare che Hendrix Genetics non ha accesso ai dati dei clienti Eggbase senza il loro consenso esplicito. Questo principio di riservatezza è parte integrante dell’utilizzo della piattaforma da parte di Hendrix Genetics e riflette l’impegno nel rispetto della privacy e della proprietà dei dati. Nick Bailey, CEO del distributore britannico Joice & Hill, ha commentato: “Eggsense è uno strumento estremamente prezioso per i nostri clienti. Quando ci viene concessa l’autorizzazione, possiamo accedere a dati che mostrano come il potenziale genetico delle nostre razze si traduca in risultati concreti sul campo. Questo ci consente di offrire un supporto tecnico ancora più mirato ed efficace”.

Nell’utilizzo di Eggsense, l’obiettivo dell’azienda è continuare a supportare i clienti esistenti, ma anche ampliare i servizi ai numerosi clienti Commercial Stock (CS) e Parent Stock (PS) di lunga data in tutto il mondo. Per entrambi, la raccolta e l’analisi dei dati rappresentano un’opportunità strategica per sbloccare e valorizzare il potenziale genetico delle loro ovaiole.
Sostenibilità ambientale: Eggbase e Hendrix Genetics insieme per un futuro più responsabile
Con il suo esclusivo Carbon Calculator, Eggbase ha sviluppato uno schema di calcolo dell’impronta ecologica dei prodotti, verificato in modo indipendente e progettato specificamente per il settore avicolo. Questo strumento fornisce il report sulle emissioni più completo disponibile per la specie avicola. L’inserimento dei dati può avvenire manualmente oppure in modo completamente integrato con le piattaforme Eggsense e Avisense, mentre la validazione da parte di esperti garantisce risultati affidabili e approfonditi. Lo strumento di calcolo di emissioni di Eggbase ha già supportato Hendrix Genetics nella misurazione dell’efficienza ambientale della razza Dekalb, evidenziando i vantaggi rispetto alle varietà rosse. I risultati di questo studio sono stati pubblicati in una recente edizione di Layer Vision e citati in diverse pubblicazioni di settore a livello globale. La crisi climatica è una sfida che riguarda tutti, ma il settore zootecnico è sotto particolare osservazione. Si stima che la produzione animale sia responsabile di circa il 12% delle emissioni globali di gas serra. Le uova e la carne avicola, tuttavia, rappresentano tra le fonti proteiche più sostenibili, con un’impronta di carbonio significativamente inferiore rispetto a quella della carne bovina, suina o ovina. In questo contesto, è fondamentale bilanciare la crescita produttiva necessaria per nutrire una popolazione mondiale
in espansione con l’urgenza di ridurre l’impatto ambientale. La riduzione delle emissioni di carbonio per chilogrammo di uova, ottenuta grazie a razze come la Dekalb, caratterizzate da alta persistenza e straordinaria efficienza alimentare, è un messaggio chiave da comunicare sia ai clienti che ai consumatori. Eggbase ha inoltre condotto una valutazione completa delle emissioni Scope 1 e 2 per il distributore britannico Joice & Hill, analizzando anche le attività dei suoi allevamenti. Lo studio ha evidenziato una riduzione del 17% delle emissioni controllabili per pulcino, grazie agli investimenti nell’elettrificazione della flotta aziendale e nella produzione di energia rinnovabile in loco.
“Siamo certi che l’intera gamma di servizi sviluppati da Eggbase rappresenti un valore significativo per la nostra base clienti globale. Siamo lieti di utilizzare Eggbase e di beneficiare degli strumenti ora a nostra disposizione” afferma Pelayo Casanovas, Amministratore Delegato della divisione Layers & Traditional Poultry Business Unit di Hendrix Genetics.
Articolo sponsorizzato Hendrix Genetics




L’INDUSTRIA AVICOLA STATUNITENSE SOTTO
PRESSIONE: UN DECENNIO TURBOLENTO
PARTE I – IL SETTORE DELLE UOVA
Tra il dicembre 2014 e il luglio 2025, l’industria avicola statunitense è stata colpita da quattro devastanti focolai di influenza aviaria (IA). In totale, il virus dell’influenza aviaria ad alta patogenicità (HPAI) è stato diagnosticato in 1.043 allevamenti avicoli commerciali (1.932 allevamenti totali, includendo i pollai domestici). Un totale di 221,7 milioni di capi avicoli è andato perso a causa delle infezioni virali o dell’abbattimento preventivo. Di questi, 178,8 milioni erano galline ovaiole, 25,7 milioni tacchini e 13,2 milioni di polli da carne (Tabella 1). In questo articolo vengono analizzati la diffusione temporale e spaziale della malattia, il suo impatto economico sulla produzione di uova e le risposte dell’industria e del governo.

➤ Hans-Wilhelm Windhorst
Professore Emerito all’Università di Vechta, Germania
■ Tabella 1 – Focolai di HPAI e perdite di animali negli USA fra aprile 2015 e luglio 2025; dati in milioni Fonte: APHIS.
di animali
Forti oscillazioni del numero di galline ovaiole
Il numero più alto di galline ovaiole nel decennio analizzato è stato raggiunto nel 2019 con 405,8 milioni, e il più basso nel marzo 2025 con appena 351 milioni1. Questo sbalzo è risultato evidente anche tra le ovaiole da consumo. Il valore più alto, 341,8 milioni, è stato anch’esso registrato nel 2019, mentre il più basso, 286,5 milioni, nel marzo 2025. La Figura 1 mostra l’andamento del numero di galline ovaiole nell’intero decennio.
Il primo grande focolaio di IA nel 2015 ha colto l’industria avicola completamente impreparata, causando la morte di 40,6 milioni di galline ovaiole, sia per infezione sia per abbattimento preventivo. Di conseguenza, tra il dicembre 2014 e il giugno 2015, il numero di galline è sceso da 316 milioni a 275 milioni. Allo stesso tempo, il consumo pro capite di uova è diminuito da 263 a 256 unità, come conseguenza del forte aumento dei prezzi dovuto alla carenza di offerta. Nel 2019, i numeri e la produzione di uova da consumo diretto sono aumentati notevolmente. La pandemia di Covid-19 ha portato a un incremento significativo del consumo pro capite fino a 293 uova, poiché molti ristoranti, mense scolastiche e universitarie erano chiusi e più pasti venivano preparati nelle abitazioni
private. Con la fine della pandemia, domanda e numero di animali sono diminuiti. Con il secondo massiccio focolaio di IA nel 2022, la diminuzione del numero di animali è continuata. In totale, oltre 40 milioni di galline sono morte a causa della malattia o sono state abbattute come misura preventiva. Nel giugno 2022 si è registrato un primo minimo con soltanto 303 milioni di ovaiole da consumo. Benché la nuova ondata di focolai l’anno successivo non fosse devastante quanto le due precedenti, ha determinato comunque un ulteriore calo dei numeri di galline, che è proseguito fino a metà 2024 a causa della riluttanza a ripopolare i capannoni. Una lettera congiunta dell’industria avicola al Segretario all’Agricoltura nel luglio 2024 ha sottolineato la situazione economica critica alla luce delle elevate perdite di animali e ha invocato un piano strategico per combattere l’IA ad alta patogenicità2.
Le aziende si erano appena riprese dai focolai quando nell’ottobre 2024 è iniziata la quarta epidemia in un decennio, che ha provocato le perdite più gravi di sempre, per oltre 50 milioni di galline ovaiole. Dal marzo 2024 al marzo 2025, il numero di ovaiole da consumo è diminuito di 11 milioni fino a soli 283,3 milioni, il livello più basso in oltre un decennio. La produzione ha subito un calo di circa 6 miliardi di uova rispetto al 2019. La conseguente carenza nel settore della vendita al dettaglio alimentare ha portato a un aumento dei prezzi senza precedenti e reso necessarie importazioni di uova per garantire l’approvvigionamento della popolazione. Il consumo pro capite è sceso a sole 271
▲ Figura 1 – Andamento del numero di galline ovaiole e della produzione di uova da consumo negli Stati Uniti dal 2014 al 2025 Elaborazione di A. S. Kauer basata su dati dell’Egg Industry Center, Iowa State University.

1 Le cifre comprendono le ovaiole da consumo e le riproduttrici.
2 https://www.uspoultry.org/position-papers/docs/ HPAI-StrategicInitative.pdf
uova nel 2024 a causa degli alti prezzi. Il calo delle ovaiole da consumo è proseguito fino a metà 2025: a giugno ne furono contate soltanto 271,3 milioni, e i prezzi delle uova nella distribuzione alimentare sono rimasti elevati. Le proteste tra la popolazione hanno reso necessario un intervento del governo. Si discuterà di questo più avanti.
Mutamenti nella distribuzione geografica
Nel decennio considerato, la la distribuzione territoriale degli allevamenti di ovaiole è mutata profondamente. Le ragioni dello spostamento della produzione sono, da un lato, le elevate perdite animali causate dalle quattro epidemie di IA e, dall’altro, i cambiamenti nei sistemi di allevamento delle ovaiole. Alcune delle principali aziende hanno ridotto i gruppi allevati in gabbie convenzionali e convertito capannoni esistenti in strutture senza gabbie oppure costruito nuovi allevamenti in località a minore rischio di infezione da IA. Ad esempio, Rose Acre Farms ha costruito due grandi complessi avicoli in Arizona nel 2018 e nel 2024, ciascuno con più di 2 milioni di posti gallina, lontani da altri allevamenti di ovaiole. Nel 2022, Cal-Maine Foods ha convertito un allevamento con 1,1 milioni di posti da gabbie convenzionali a gestione a terra (grandi aviari) e ha costruito un altro nuovo allevamento per 2,2 milioni di galline a Delta (Utah) (Windhorst 2018, 2023).
Le quattro epidemie di IA sono differite sia nelle loro linee temporali sia nella loro diffusione spaziale. L’Iowa è stato colpito principalmente nel 2015; Iowa e Nebraska nel 2022; Ohio, California e Iowa nel 2023; e ancora California, Ohio e Iowa nel 2024/25. Le rotte migratorie percorse dagli uccelli selvatici infetti dal virus dell’influenza aviaria hanno avuto un ruolo determinante nella diffusione geografica e temporale delle epidemie3
Un confronto dei dieci principali Stati per numero di galline ovaiole nel 2014, 2019 e 2024 mostra (Figura 2) che l’Iowa ha perso la sua posizione dominante. Tra il 2014 e il 2024, il numero di galline ovaiole è sceso da 59,2 milioni a 43,8 milioni, ossia del 26,0%. La quota sul numero totale di galline degli Stati Uniti è diminuita dal 16,4% all’11,7%. Al contrario, il numero di galline in Ohio è salito da 29,1 milioni a 40,7 milioni, pari al 39,2%, e la quota dello Stato sul numero totale è aumentata dall’8,1% al 10,8%.
L’Indiana ha mostrato una dinamica simile. Il grande sconfitto è stata la California, il cui numero di ovaiole da consumo è sceso dal 2,7% all’1,4% tra aprile 2014 e aprile 2024. Come l’Ohio, la California è stata particolarmente colpita dall’epidemia del 2024/25. Tra aprile 2024 e aprile 2025, la California ha perso 4,1 milioni di ovaiole da
3 Windhorst 2015, 2022a, 2023, 2024, 2025.

▲ Figura 2 – Quota dei dieci principali stati sul numero di galline ovaiole negli Stati Uniti nel 2014, 2019 e 2024 Elaborazione di A. S. Kauer basata su dati USDA, NASS.
consumo e non è più tra gli Stati leader. Ci vorranno diversi anni per ricostituire gli allevamenti. Resta una questione aperta se il livello precedente potrà mai essere recuperato.
Verso l’allevamento senza gabbie
Il dibattito in corso e inizialmente molto controverso sul divieto delle gabbie convenzionali per le galline ovaiole, avviato nel 2008 con la Proposition 2 introdotta dalla Humane Society of the United States
in California, non sarà qui trattato in dettaglio (si veda Windhorst, 2009) 4 . Negli anni successivi, sono state sottoposte a voto ulteriori proposte e nel 2012 la Proposition 12 è stata approvata tramite referendum. Nonostante la resistenza iniziale e un abbandono molto lento delle gabbie convenzionali, la conversione o costruzione di strutture senza gabbie ha guadagnato slancio. Un ruolo importante è stato svolto dalle decisioni delle principali catene di distribuzione alimentare, alberghiere e delle aziende di trasformazione delle uova di vendere o utilizzare soltanto uova provenienti da allevamenti senza gabbie. Sulla scia della pandemia di Covid-19 e delle epidemie di IA, la transizione verso la produzione senza gabbie si è accelerata. Se nel 2014 soltanto 16,1 milioni, ovvero il 5,4%, delle galline ovaiole, erano allevate in sistemi senza gabbie, entro la metà del 2025 questo valore ha già raggiunto circa 126 milioni, ossia il 43,9% (Figura 3). Si può presumere che entro il 2030 due terzi di tutte le ovaiole saranno allevati in sistemi senza gabbie. La legislazione emergente riguardante i risarcimenti finanziari per gli allevamenti a seguito di un focolaio di IA e delle relative perdite animali potrebbe anch’essa svolgere qui un ruolo decisivo.
Carenza di uova, aumento dei prezzi e importazioni
Ciascuna delle quattro epidemie di IA ha portato a un forte calo della produzione di uova. Di conseguenza, i ricavi delle aziende agricole non colpite dall’IA sono aumentati in modo significativo. I prezzi non si sono stabilizzati fino al ripopolamento degli allevamenti, ma nella maggior parte dei casi sono rimasti al di sopra del livello iniziale per diversi mesi (Tabella 2).
▲ Tabella 2 – Andamento dei valori delle uova al prezzo della produzione e al prezzo all’ingrosso dopo i focolai di influenza aviaria del 2023 e del 2024/25 negli Stati Uniti; dati in $ per dozzina Fonte: Egg Industry Center, Iowa State University.
Mese Prezzo alla produzione Prezzo all’ingrosso* 2022/2023 2024/2025 2024/2025
Settembre
Ottobre
Novembre
Dicembre
Gennaio
Febbraio
Marzo
Aprile
*media del Midwest
▲ Tabella 3 – L’andamento delle importazioni di uova e ovoprodotti negli Stati Uniti dal 2014 al 2024 Fonte: USDA, FATUS GATS.
Anno Importazioni di uova in guscio
(milioni di uova)
Importazioni di ovoprodotti
Nelle grandi aree urbane del nord-est e in California, i prezzi al dettaglio hanno toccato in alcuni momenti i 10 dollari a dozzina, provocando proteste da parte della popolazione e costringendo il governo a intervenire. L’industria degli ovoprodotti, in particolare, ha avuto problemi a consegnare le quantità contrattualizzate perché non riusciva a procurarsi le uova necessarie, o poteva farlo solo a un prezzo molto più elevato. Come alcune catene di supermercati, essa ha fatto pressioni per importare uova al fine di poter continuare a produrre a un livello che coprisse i costi. Poiché l’epidemia di influenza aviaria del 2015 colse gli allevatori di galline ovaiole impreparati, il deficit di approvvigionamento fu particolarmente elevato. Tra la fine del 2015 e l’inizio del 2016 furono importate oltre 1,1 miliardi di uova per un valore di 124 milioni di dollari e 35.000 t di ovoprodotti per un valore di 106 milioni di dollari. Sebbene dopo le epidemie del 2022 e del 2023/24 le importazioni
4 https://ballotpedia.org/California_Proposition_12,_Farm_ Animal_Confinement_Initiative_(2018)
siano state inferiori in volume, esse hanno raggiunto un valore complessivo di 124,7 milioni di dollari (Tabella 3).
La risposta del governo
Nel dicembre 2024, l’APHIS ha pubblicato nuove linee guida che subordinano i futuri indennizzi per le perdite causate dall’influenza aviaria al rispetto di precise condizioni5. Tra queste, l’obbligo per un allevamento di dimostrare di aver rafforzato le proprie misure di biosicurezza prima di poter ripopolare le strutture dopo un abbattimento; la verifica è affidata ad audit dell’agenzia stessa. L’obiettivo è innalzare gli standard di prevenzione6
5 https://www.aphis.usda.gov/print/pdf/node/7419
6 https://www.aphis.usda.gov/news/agency-announcements/ aphis-announces-updates-indemnity-program-highly-pathogenic-avian
Il 18 febbraio 2025, un gruppo di 16 senatori di entrambi i partiti ha scritto al Segretario all’Agricoltura chiedendo lo sviluppo di una strategia lungimirante per la produzione di vaccini e il loro impiego nell’allevamento di galline ovaiole e tacchini. Inoltre, dovrebbero essere avviati negoziati con i partner commerciali per convincerli della necessità di vaccinare la popolazione avicola senza che la vaccinazione ostacoli o impedisca il commercio7. In risposta, il Dipartimento dell’Agricoltura degli Stati Uniti ha messo a disposizione, nell’aprile successivo, 100 milioni di dollari per consentire agli scienziati di sviluppare nuovi vaccini per proteggere gli allevamenti avicoli e per ricercare la diffusione del virus IA negli uccelli selvatici e la sua trasmissione ai branchi. Questo dovrebbe, se non prevenire del tutto le epidemie ricorrenti, almeno limitarne l’entità. Inoltre, sono stati annunciati in un piano strategico 500 milioni di dollari per misure di biosicurezza e 400 milioni di dollari di aiuti finanziari per gli allevatori colpiti8
Nel marzo 2025 è stato istituito un gruppo di lavoro composto da rappresentanti dell’industria avicola, delle organizzazioni commerciali e dei veterinari statali. Il suo compito è redigere un piano per la vaccinazione del pollame, che è stato pubblicato nel luglio 2025 e trasmesso
7 https://www.ernst.senate.gov/imo/media/doc/letter_to_ usda_in_response_to_hpai_outbreaks.pdf
8 Irritanti, in questo contesto, sono le dichiarazioni del Segretario dell’Agricoltura, Rollins, e del Segretario della Salute e dei Servizi Umani, Kennedy, che non sostenevano più lo sviluppo dei vaccini e la vaccinazione preventiva per combattere l’influenza aviaria (AI). Il Segretario Kennedy ha suggerito che gli allevamenti non dovessero essere abbattuti in
all’USDA e alle organizzazioni dell’industria avicola per eventuali commenti9. Finora non sono disponibili risultati. I produttori di uova sperano che l’industria del broiler e del tacchino rinunci alla propria resistenza alla vaccinazione, che giustifica dal 2014 con il timore che i principali Paesi consumatori interrompano le importazioni.
Sintesi e prospettive
Quattro epidemie di influenza aviaria ad alta patogenicità hanno colpito gli allevatori avicoli negli Stati Uniti nell’ultimo decennio. In totale, i 1.043 focolai nelle aziende commerciali hanno comportato la perdita di oltre 221 milioni di animali a causa dell’infezione o dell’abbattimento preventivo, tra cui 178,8 milioni di galline ovaiole. Le ingenti perdite economiche subite dalle aziende agricole e dall’industria di trasformazione, così come i problemi di approvvigionamento per la popolazione, hanno costretto il governo a intervenire.
Oltre a fornire finanziamenti per la ricerca e lo sviluppo di vaccini, è in fase di elaborazione un piano per la vaccinazione preventiva che si auspica venga adottato in collaborazione con l’industria avicola.
via preventiva, ma infettati, in modo da poter poi selezionare le linee di riproduzione basandosi sugli animali sopravvissuti, poiché apparentemente avevano sviluppato una resistenza. Questa proposta ha incontrato una forte opposizione da parte dell’industria avicola (The Highly Pathogenic Avian Influenza (HPAI) Outbreak in Poultry, 2022-Present, p. 10).
9 Informazione resa a titolo personale da parte della Dr. Denise Heard, Vice President Research, U. S. Poultry & Egg Association (July 7th, 2025).


Fonti di dati e approfondimenti
Congressional Research Service. (2025). The highly pathogenic avian influenza (HPAI) outbreak in poultry, 2022-present https://www.congress. gov/crs_external_products/R/PDF/R48518/ R48518.1.pdf
United Egg Producers. (n.d.). Facts & stats https://unitedegg.com/facts-stats
United States Department of Agriculture, Foreign Agricultural Service. (n.d.). U.S. foreign agricultural trade https://apps.fas.usda.gov/gats/ default.aspx?publish=1
United States Department of Agriculture, National Agricultural Statistics Service. (2024). Chicken and eggs: Annual summary 2024 https:// downloads.usda.library.cornell.edu/usda-esmis/ files/1v53jw96n/4b29d373g/4455b918n/ ckegan25.pdf
U.S. Poultry & Egg Association. (n.d.). Economic data. https://www.uspoultry.org/economic-data Windhorst, H.-W. (2009). Impacts of the California referendum on banning cages and perspectives for the U.S. egg industry. Zootecnica, 31(2), 12–23.
Windhorst, H.-W. (2015). Avian influenza outbreaks in Iowa layer farms and their economic impacts. Zootecnica International, 37(12), 28–35.
Windhorst, H.-W. (2018). The USA on their way to cage-free egg production: The Lone Cactus egg farm in Bouse (Arizona). Zootecnica International, 40(2), 16–19.
Windhorst, H.-W. (2022). A new milestone in US egg production. Poultry World, 38(9), 26–28.
Windhorst, H.-W. (2022a). Verheerender Seuchenzug im Land: Eine räumliche und zeitliche Analyse der Aviären Influenza in den USA im Jahr 2022. Fleischwirtschaft, 102(9), 23–27.
Windhorst, H.-W. (2023). 2022 war Vieles anders: Eine Dokumentation und Analyse des AI-Seuchenzuges in den USA. Fleischwirtschaft, 103(4), 42–46.
Windhorst, H.-W. (2024). Third avian influenza outbreak in the USA within 10 years: The 2023–2024 epidemic. Zootecnica International, 46(9), 28–33.
Windhorst, H.-W. (2025). Fourth AI epidemic in the USA in the past decade – the epidemic in winter 2024/25. Zootecnica International, 46(7/8), 22–27.


QUANDO L’APPORTO PROTEICO È ECCESSIVO?
La quota proteica rappresenta gran parte del costo dell’alimentazione dei polli da carne e, se non utilizzata in modo efficiente, riduce i ricavi. Adeguare l’apporto proteico alla performance del pollame non è solo essenziale per massimizzare i profitti, ma anche per ridurre le emissioni di azoto dagli allevamenti. Pertanto, abbinare l’assunzione proteica al fabbisogno metabolico di aminoacidi del pollo da carne può giovare al portafoglio dell’allevatore e allo stesso tempo rendere la produzione più sostenibile dal punto di vista ambientale.
➤ Aitor Arrazola
Biologo ricercatore, Ph.D. in Benessere e comportamento animale
Principali promotori dell’accrescimento muscolare
I polli da carne di oggi sono geneticamente predisposti a ottenere una crescita rapida e magra in poche settimane
grazie allo sviluppo accelerato del muscolo. Più alta è la pressione metabolica per la crescita muscolare, maggiore è il fabbisogno di proteina grezza (CP) nella dieta per il mantenimento e lo sviluppo (e viceversa). Per questo motivo, fornire diete bilanciate ai polli da carne è essenziale per sostenere la sintesi proteica necessaria all’aumento della massa muscolare. Nel caso dei polli in accrescimento, la domanda di proteine nella dieta è notevole nelle prime settimane di vita (23% di CP), per poi scendere al 18% di CP durante la fase di finissaggio, grazie all’aumento

dell’ingestione giornaliera di mangime. Inoltre, le raccomandazioni proteiche differiscono in base alla linea genetica per raggiungere obiettivi di performance specifici di linea. Il contenuto proteico raccomandato può variare dal 15% di CP per polli a lenta crescita al 21,5% di CP per polli a crescita rapida, in relazione alle diverse curve di crescita. Tuttavia, superare i fabbisogni metabolici non favorisce ulteriormente lo sviluppo muscolare oltre i limiti genetici. Oltre al contenuto di proteina grezza, la concentrazione e il bilanciamento degli aminoacidi sono fondamentali affinché i polli da carne raggiungano una rapida crescita muscolare. Durante la digestione, le proteine vengono scomposte in peptidi e aminoacidi per l’assorbimento e, una volta entrati nell’organismo, gli aminoacidi vengono assemblati per la sintesi proteica. Le proteine sono strutture tridimensionali composte da specifici aminoacidi, e la sintesi proteica può bloccarsi se mancano alcuni aminoacidi, che agiscono da nutrienti limitanti per il raggiungimento degli obiettivi produttivi. Infatti, i polli non possono sintetizzare alcuni aminoacidi (ad es. lisina) che devono essere acquisiti regolarmente con la dieta per garantire il corretto funzionamento e le performance: sono i cosiddetti aminoacidi essenziali.

Una concentrazione subottimale di aminoacidi essenziali (e del loro rapporto) può arrestare la sintesi proteica, la velocità
di crescita e l’efficienza alimentare, indipendentemente dall’apporto di proteina grezza. Le diete a base di cereali (grano, orzo, avena, mais), combinate con ingredienti ricchi di proteine (leguminose), possono aumentare il livello di proteina grezza ma risultare comunque carenti di aminoacidi essenziali a causa di un bilanciamento inadeguato. Per questo motivo, le diete dei polli da carne vengono spesso integrate con aminoacidi essenziali per soddisfare i fabbisogni, ottenendo così un’alimentazione bilanciata e di maggiore valore nutrizionale. Per i polli a crescita rapida, le ricerche dell’ultimo decennio dimostrano che la concentrazione di lisina può rappresentare un
PANNELLO IN PLASTICA PER
SISTEMA PAD
Il sistema Pad Climate LUBING è fatto completamente in plastica. Viene usato in tutte le situazioni nelle quali si necessita un sistema ad alta efficienza.

• Per il raffreddamento evaporativo dei capannoni di polli e suini.
• Eccellente capacità di raffreddamento - design brevettato.
• Facile da pulire.
• Lunga durata
• Minima perdita di pressione
• Alta resistenza agli UV
• Impermeabilità alla luce

Via Marco Polo, 33 - 35011 - Campodarsego (PD) ITALIA +39 0499202290 - lubingsystem.com - info@lubing.it


nutriente limitante per la resa del petto, e che la quantità di questo aminoacido essenziale (e il suo rapporto con gli altri aminoacidi) dovrebbe essere attentamente monitorata in relazione alle specifiche nutrizionali della linea e all’ingestione/apporto di mangime. Nonostante comporti un costo aggiuntivo, l’integrazione di aminoacidi essenziali va considerata un investimento per garantire un corretto equilibrio aminoacidico e quindi le performance dei polli da carne.
Adeguare gli aminoacidi della dieta ai fabbisogni metabolici
Una volta soddisfatti i fabbisogni metabolici quotidiani di aminoacidi (per digeribilità proteica, mantenimento e crescita muscolare), gli aminoacidi in eccesso vengono eliminati e metabolizzati in carboidrati e acidi grassi. Pertanto, eccedere i fabbisogni proteici e di aminoacidi essenziali oltre le necessità metaboliche dei polli può risultare antieconomico a causa dell’elevato costo dell’alimentazione, senza benefici aggiuntivi sulle performance. In effetti, le performance non migliorano quando il contenuto proteico supera il 20% nelle diete di finissaggio e lo smaltimento degli aminoacidi in eccesso può gravare metabolicamente sugli animali.
Il contenuto proteico della dieta dovrebbe quindi essere considerato un valore di riferimento per coprire i fabbisogni di aminoacidi non essenziali, mentre la qualità proteica del mangime (in termini di quantità, equilibrio e digeribilità degli aminoacidi essenziali) va attentamente valutata e, se necessario, integrata con aminoacidi essenziali. Questo è particolarmente importante perché i polli alimentati con diete a basso contenuto di proteina grezza possono convertire gli aminoacidi essenziali in non essenziali qualora questi ultimi diventino nutrienti limitanti, con conseguenze sfavorevoli anche sul piano economico. Per questo motivo è consigliata una formulazione della dieta basata sui fabbisogni aminoacidici, così da ridurre il livello di proteina grezza e migliorare le performance. Tuttavia, nella scelta della fonte proteica, del livello dietetico e dell’integrazione di aminoacidi, è altrettanto importante bilanciare il costo degli ingredienti con il prezzo della carne.
Raggiungere l’efficienza proteica
Mantenere livelli adeguati di proteine e aminoacidi è essenziale per conservare e sviluppare la massa muscolare, mentre eccedere i fabbisogni metabolici è costoso, inefficiente e meno sostenibile dal punto di vista ambientale. Gli aminoacidi inutilizzati vengono degradati a urea e poi convertiti in acido urico per l’escrezione, che a sua volta si trasforma in ammoniaca nella lettiera. Questo comporta un aumento della concentrazione di ammoniaca nei capannoni, con possibili rischi di malattie respiratorie e altri disturbi
per i polli e per il personale. In effetti, le buone pratiche di gestione dei polli da carne indicano che una riduzione dell’1% della proteina grezza (purché vengano rispettati i fabbisogni di aminoacidi essenziali) può diminuire le emissioni di ammoniaca del 10-20% senza effetti negativi sulle performance degli animali. Passare da diete ad alto contenuto proteico a diete con la giusta quantità di proteine e aminoacidi può rappresentare una strategia pratica per massimizzare l’efficienza proteica dei polli da carne (quante proteine vengono ingerite rispetto a quante effettivamente utilizzate). In questa prospettiva, l’alimentazione per fasi può aiutare ad adattare proteine e aminoacidi della dieta ai fabbisogni metabolici, man mano che l’ingestione di mangime aumenta con l’età. Mantenere questo concetto di efficienza proteica può aiutare i produttori a ridurre gli sprechi proteici, mitigare l’impronta di azoto, migliorare la qualità della lettiera e dell’aria (e i problemi di salute correlati), ridurre le spese di alimentazione e mantenere performance produttive elevate.


SALVAGUARDIA
NELL’INTERO PROCESSO PRIMARIO ◗
DELLA RESA PRODUTTIVA
Lo stabilimento di trasformazione rappresenta il cuore di un’azienda avicola, in quanto è l’unica area che genera valore, mentre tutte le altre sono soltanto centri di costo. La capacità di creare valore dipende strettamente dall’andamento della resa di lavorazione, che costituisce il principale motore economico dell’attività. Di conseguenza, garantirne la tutela deve essere la priorità assoluta per tutto il personale dell’azienda.
➤ Ing. Fabio G. Nunes
Consulente per la lavorazione delle carni avicole, Brasile
I polli da carne destinati al consumo umano vengono eviscerati prima di arrivare sul mercato. L’eviscerazione viene eseguita lungo l’area del processo primario, dove sangue, piume, intestini e altre parti non commestibili vengono rimossi dalle carcasse. La rimozione dei visceri comporta una perdita di peso intrinseca e inevitabile che, in modo ideale, dovrebbe essere l’unica subita dalle carcasse durante il processo primario. Tuttavia, la realtà è diversa, poiché alcune altre variabili, come l’uniformità dei lotti, la manutenzione dei macchinari e la scarsa efficienza operativa, possono causare ulteriori perdite e danneggiare le carcasse, portando complessivamente a una diminuzione della resa di lavorazione. Pertanto, garantire la prestazione ottimale del processo primario è fondamentale per proteggere la resa di lavorazione e, allo stesso tempo, anche i risultati economici dell’azienda.

L’uniformità degli animali è un prerequisito chiave per le prestazioni ottimali del processo primario. Essa facilita la regolazione dei macchinari sulla carcassa e rende l’interazione più precisa e fluida, contribuendo così a ridurre il rischio di perdite di peso dovute a danni e rifilature. Per questo motivo, monitorare costantemente l’uniformità della materia prima e lavorare per migliorarla porta grandi benefici alla resa di lavorazione.
Alla postazione di appensione, i polli devono essere appesi per le zampe al momento dell’aggancio. Le dimensioni dei ganci variano in base al peso vivo medio degli animali per ridurre al minimo la pressione sulle zampe e il rischio di ematomi quando i piedi scivolano lungo i ganci. Bisogna
evitare la perdita di peso dovuta a tagli errati delle giunture rimuovendo i piedi di ritorno dalla linea prima dell’aggancio. La barra di contenimento toracico deve essere fissata in modo da accompagnare i polli dall’appensione fino allo storditore, ed essere correttamente dimensionata e installata per evitare lo sbattimento delle ali, che altrimenti provocherebbe ematomi. Il trasportatore aereo deve essere installato nel modo più rettilineo possibile tra l’appensione e lo stordimento, per evitare un intenso sbattimento delle ali dovuto al disagio provocato da curve e pendenze. Installare lo storditore in modo che i polli immergano la testa – e mai le ali – nell’acqua, e regolare continuamente l’altezza affinché gli animali immergano solo metà del collo nella vasca. Queste precauzioni evitano ematomi dovuti al contatto di ali e petto con l’acqua. Regolare lo storditore in conformità con la normativa locale sul benessere animale, senza però causare danni alle carcasse. Durante lo sgozzamento, i vasi sanguigni devono essere recisi il più vicino possibile alla mandibola per preservare la maggior parte della pelle del collo e lasciare intatte trachea e midollo spinale, garantendo un dissanguamento ottimale

e una scottatura e spiumatura efficaci e regolari. Il tempo di dissanguamento deve essere regolato per evitare la presenza di animali morti, ma non prolungato al punto da richiedere condizioni di scottatura e spiumatura troppo aggressive, che danneggerebbero le carcasse. Il rapporto tempo–temperatura della scottatura deve armonizzarsi con la velocità della linea di macellazione, il peso della carcassa, il colore della pelle e la tecnologia dello scottatore, per ottenere risultati ottimali. Un’impostazione errata può produrre carcasse non scottate a sufficienza, che richiedono una spiumatura più dura con maggior rischio di danni a pelle e ali, oppure carcasse eccessivamente scottate, con pelle danneggiata, petto bruciato e strato di grasso sottocutaneo sciolto, che può comportare una perdita di peso compresa tra lo 0,5% e l’1,5%.
Una capacità di spiumatura insufficiente equivale a zampe danneggiate e pelle lacerata, con conseguente aumento delle rifilature e diminuzione della resa. Un rapporto ampiamente accettato è di uno spiumatore a 16 piastre per ogni 3.000 polli/ora. Gli spiumatori devono essere costantemente regolati sulle carcasse per ottimizzare la spiumatura riducendo al minimo i danni. Le dita di gomma mancanti, rotte o usurate devono essere sostituite quotidianamente per migliorare la spiumatura e ridurre lacerazioni cutanee e fratture degli arti. È consigliato l’uso di acqua tiepida in tutti gli spiumatori. Una griglia sotto l’intera linea di spiumatura evita che gli animali che si staccano dai ganci vengano trascinati con le piume all’impianto di sottoprodotti. Un corretto programma di sospensione dell’alimentazione è di fondamentale importanza per ridurre il rischio di contaminazioni lungo la linea di eviscerazione, e quindi
ridurre le perdite di peso dovute al recupero di carcasse contaminate. Tuttavia, per quanto importante, ciò non è sufficiente e deve essere integrato da una corretta gestione dei macchinari per massimizzare la resa di lavorazione. La lama del tagliatore cloacale deve essere adeguata alla dimensione delle carcasse e mantenuta affilata per garantire un taglio netto e completo senza strappare la pelle. La macchina deve essere regolata costantemente per evitare contaminazioni da intestini tagliati e perdite di materiale fecale dalla cloaca, che comporterebbero perdite di peso dovute al recupero delle aree contaminate.
È necessario monitorare i risultati dell’apritore per evitare che escano dalla macchina intestini tagliati e per garantire che l’apertura consenta una successiva eviscerazione accurata senza danneggiare i visceri commestibili né provocare fuoriuscite di bile sulla carcassa.
Durante l’eviscerazione, mantenere il grasso addominale attaccato alle carcasse – poiché rappresenta tra il 2% e il 4% del peso – e massimizzare la raccolta dei visceri commestibili – che costituiscono circa il 7% del peso vivo –contribuisce ad aumentare la resa.
L’estrazione della trachea e del gozzo deve avvenire con il minimo impatto sullo strato interno altamente igroscopico della pelle del collo, che influisce sulla capacità di assorbimento dell’acqua durante la refrigerazione in acqua. Come si è visto, preservare l’integrità delle carcasse, e quindi contribuire a migliorare la resa e i risultati economici dell’azienda, non è un compito facile né la responsabilità di un’unica area. Per avere successo, la missione richiede un approccio di squadra con il contributo costante dei diversi attori lungo la catena produttiva, dall’allevamento allo stabilimento.
Riproduttori e Incubatoi










Riproduttori













Guida internet
ADM Animal Nutrition Italy S.r.l. it.support@wisium.com
www.admanimalnutrition.com
Agritech commerce@agritech.it www.agritech.it
Albitalia infotecniche@albitalia.com www.albitalia.com
Albors info@albors.it www.albors.it
Ali Lohmann info@lohmann.it www.alilohmann.com
Arion Fasoli info@arionfasoli.com www.arionfasoli.com
Aviagen info@aviagen.com www.aviagen.com
Aviagen Turkeys Ltd turkeysltd@aviagen.com www.aviagenturkeys.com
Aza International info@azainternational.it www.azainternational.it
Babolna TETRA info@babolnatetra.com www.babolnatetra.com
Barbieri Belts info@barbieri-belts.com www.barbieribelts.com
Biochem bertarelli@biochem.net www.biochem.net
Big Dutchman big@bigdutchman.de www.bigdutchman.com
Biolab 2000 biolabvr@tiscalinet.it www.biolab2000.it
Carfed International Ltd carfed@carfed.co.uk
Carfed International Ltd Italy carfed@carfed.it www.carfed.it
Chick Farm Europe info@chickeurope.com www.novogen-layers.com
Cizo info@cizo.it www.cizo.it
Clerici Gino S.r.l. info@clerici.it www.clerici.it
Cobb Europe info@cobb-europe.com www.cobb-vantress.com
Codaf info@codaf.net www.codaf.net
Corti Zootecnici S.r.l. info@cortizootecnici.com www.cortizootecnici.it dsm-firmenich stefano.zappa@dsm-firmenich.com www.dsm-firmenich.com
Elanco italia_elanco@elanco.com www.elanco.com
EuroTier eurotier@dlg.org www.eurotier.com
Facco Poultry Equipment facco@facco.net www.facco.net
FIEM fiem@fiem.it www.fiem.it
FierAgricola Verona fieragricola@veronafiere.it www.fieragricola.it
FierAvicola info@fieravicola.com www.fieravicola.com
Gasolec sales@gasolec.com www.gasolec.com
Giordano Global info@giordanoglobal.com www.giordanoglobal.com/it/
Hendrix Genetics info@hendrix-genetics.com www.hendrix-genetics.com
Hubbard contact.emea@hubbardbreeders.com www.hubbardbreeders.com
Hy-line info@hylineitalia.com www.hyline.com/italian
Impex Barneveld BV info@impex.nl www.impex.nl
Intracare info@intracareitaly.com www.intracare.nl
Lallemand animalitaly@lallemand.com www.lallemandanimalnutrition.com
Lubing System info@lubing.it www.lubingsystem.com
Marel info.poultry@marel.com www.marel.com/en/poultry
Mbe Breeding Equipment info@mbefabriano www.mbefabriano.it
Meyn sales@meyn.com www.meyn.com
MSD Animal Health S.r.l. www.msd-animal-health.it
Newpharm info@newpharm.it www.newpharm.it
Officine Meccaniche Vettorello luciano@officinevettorello.it www.officinevettorello.com
Petersime N.V. info@petersime.com www.petersime.com
Riva Selegg info@rivaselegg.com www.rivaselegg.com
Royal Pas Reform info@pasreform.com www.pasreform.com
Roxell info@roxell.com www.roxell.com
Reventa info.reventa@munters.de www.reventa.de
Sacco S.r.l. info@saccosystem.com www.saccosystem.com
Schropper office@schropper.at www.schropper.at
Ska ska@ska.it www.ska.it
Sime-Tek info@sime-tek.com www.sime-tek.com
Space info@space.fr www.space.fr
Specht Poultry Equipment www.specht-germany.com info@specht-germany.com
Sperotto info@sperotto-spa.com www.sperotto-spa.com
Tezza tezza@tezza.it www.tezza.it
TPI-Polytechniek info@tpi-polytechniek.com www.tpi-polytechniek.com
Valli info@valli-italy.com www.valli-italy.com
Val-co intl.sales@val-co.com www.val-co.com
VDL Agrotech info@vdlagrotech.nl www.vdlagrotech.com
VDL Jansen info@vdljansen.com www.vdljansen.com
Vencomatic Group B.V. info@vencomaticgroup.com www.vencomaticgroup.com
Vétoquinol Italia italy_ascor@vetoquinol.com ascor.vetoquinol.it
Victoria victoria@victoria-srl.com www.incubatricivictoria.com

Editore
Amministrazione e redazione: Zootecnica di Marianna Caterino Via del Forestello n. 8
50063 Figline Incisa Valdarno (FI) P.IVA IT 07439250486
Telefono +39 055 010 7041 Web: www.zootecnica.it
Abbonamento
www.zootecnica.it/abbonamenti/ 1 anno / 11 numeri: Euro 50 Costo singola copia 6 €
L’abbonamento avrà inizio dal primo numero successivo al pagamento e darà diritto a ricevere tutti gli 11 numeri della durata dell’abbonamento annuale. La spedizione avviene in abbonamento postale. L’IVA sugli abbonamenti è assolta dall’editore in conformità all’art. 74, primo comma, lettera C del DPR 26/10/1972 n. 633 e successive modificazioni.
Seguici
Resta sempre aggiornato sulle ultime novità e tendenze del settore avicolo.
Seguici su Linkedin


Seguici su Facebook


Edizione italiana Anno I • Dicembre 2025


